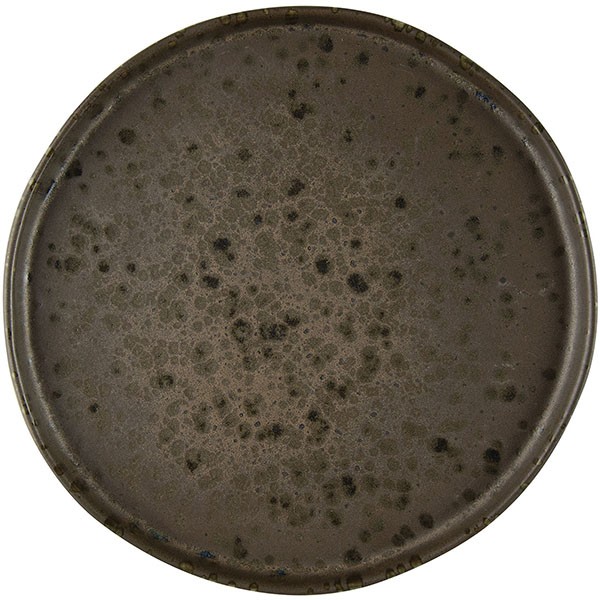

Тарелка «Фобос» мелкая, керамика, 20,5 см, коричневый
1,685.00 р.
1,832.00 р.
-8%
Наличие:
Товар точно есть на складе
Артикул: DC 3013783
Арт. производителя: LPHO019MA002205
Материал: Керамика
Группы товаров: Предметы сервировки, Посуда, Профессиональная посуда, Прочие предметы сервировки, Тарелки
Производитель: Le CoQ
Серия: Phobos
Страна производителя: Италия
Описание товара
Материал: Керамика
Производитель: Le CoQ
Серия: Phobos (Фобос)
Страна производства: Италия
Цвет: Коричневый
Можно использовать в посудомоечной машине: Да
Можно использовать в микроволновой печи (СВЧ): Да
Диаметр: 20.5 см
Тип декора: Точка
Форма: Круглая
Назначение: Для вторых блюд
Тип борта: Вертикальный
Категория: Тарелки плоские
Ключевые слова: Тарелка
Производитель: Le CoQ
Серия: Phobos (Фобос)
Страна производства: Италия
Цвет: Коричневый
Можно использовать в посудомоечной машине: Да
Можно использовать в микроволновой печи (СВЧ): Да
Диаметр: 20.5 см
Тип декора: Точка
Форма: Круглая
Назначение: Для вторых блюд
Тип борта: Вертикальный
Категория: Тарелки плоские
Ключевые слова: Тарелка
Блюдо для подачи «Фобос» для крем-брюле, керамика, 200 мл, черный, синий
DC 3035220
1,643.00 р. 1,748.00 р.